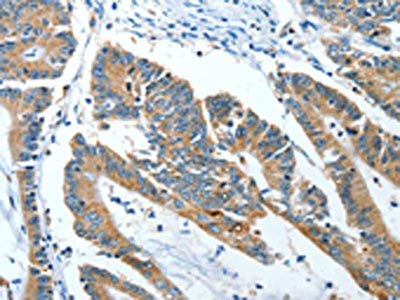

ANGPT1 Antibody
-
中文名稱:ANGPT1兔多克隆抗體
-
貨號:CSB-PA235182
-
規格:¥1100
-
圖片:
-
The image on the left is immunohistochemistry of paraffin-embedded Human thyroid cancer tissue using CSB-PA235182(ANGPT1 Antibody) at dilution 1/50, on the right is treated with fusion protein. (Original magnification: ×200)
-
The image on the left is immunohistochemistry of paraffin-embedded Human colon cancer tissue using CSB-PA235182(ANGPT1 Antibody) at dilution 1/50, on the right is treated with fusion protein. (Original magnification: ×200)
-
-
其他:
產品詳情
-
Uniprot No.:
-
基因名:
-
別名:AGP 1 antibody; AGP1 antibody; AGPT antibody; ANG 1 antibody; ANG antibody; ANG-1 antibody; ANG1 antibody; Angiopoietin-1 antibody; Angiopoietin1 antibody; ANGP1_HUMAN antibody; ANGPT 1 antibody; Angpt1 antibody; KIAA0003 antibody; OTTHUMP00000227592 antibody; OTTHUMP00000227599 antibody; OTTHUMP00000227600 antibody
-
宿主:Rabbit
-
反應種屬:Human,Mouse,Rat
-
免疫原:Fusion protein of Human ANGPT1
-
免疫原種屬:Homo sapiens (Human)
-
標記方式:Non-conjugated
-
抗體亞型:IgG
-
純化方式:Antigen affinity purification
-
濃度:It differs from different batches. Please contact us to confirm it.
-
保存緩沖液:-20°C, pH7.4 PBS, 0.05% NaN3, 40% Glycerol
-
產品提供形式:Liquid
-
應用范圍:ELISA,IHC
-
推薦稀釋比:
Application Recommended Dilution ELISA 1:2000-1:5000 IHC 1:50-1:200 -
Protocols:
-
儲存條件:Upon receipt, store at -20°C or -80°C. Avoid repeated freeze.
-
貨期:Basically, we can dispatch the products out in 1-3 working days after receiving your orders. Delivery time maybe differs from different purchasing way or location, please kindly consult your local distributors for specific delivery time.
-
用途:For Research Use Only. Not for use in diagnostic or therapeutic procedures.
相關產品
靶點詳情
-
功能:Binds and activates TEK/TIE2 receptor by inducing its dimerization and tyrosine phosphorylation. Plays an important role in the regulation of angiogenesis, endothelial cell survival, proliferation, migration, adhesion and cell spreading, reorganization of the actin cytoskeleton, but also maintenance of vascular quiescence. Required for normal angiogenesis and heart development during embryogenesis. After birth, activates or inhibits angiogenesis, depending on the context. Inhibits angiogenesis and promotes vascular stability in quiescent vessels, where endothelial cells have tight contacts. In quiescent vessels, ANGPT1 oligomers recruit TEK to cell-cell contacts, forming complexes with TEK molecules from adjoining cells, and this leads to preferential activation of phosphatidylinositol 3-kinase and the AKT1 signaling cascades. In migrating endothelial cells that lack cell-cell adhesions, ANGT1 recruits TEK to contacts with the extracellular matrix, leading to the formation of focal adhesion complexes, activation of PTK2/FAK and of the downstream kinases MAPK1/ERK2 and MAPK3/ERK1, and ultimately to the stimulation of sprouting angiogenesis. Mediates blood vessel maturation/stability. Implicated in endothelial developmental processes later and distinct from that of VEGF. Appears to play a crucial role in mediating reciprocal interactions between the endothelium and surrounding matrix and mesenchyme.
-
基因功能參考文獻:
- ERG is an endothelial transcriptional effector activated downstream of Ang1 to promote Notch signalling and vascular stability. Ang1 is able to phosphorylate ERG via PI3K/Akt, and this promotes the formation of an ERG-beta catenin complex, which binds multiple sites in the Dll4 locus and drives Dll4 expression. PMID: 28695891
- miR-876-5p suppressed proliferation by restraining the expression of Ang-1, which would regulate the phosphorylation level of PI3K, AKT, mTOR and ERK in psoriasic cells. PMID: 29864894
- hyperoxia as well as increased TGFbeta signaling is a major contributor to the increased levels of miR34a, which mediate injury via angiopoietin-1 in neonatal lungs PMID: 29079808
- High Angpt2 and low Angpt1 levels were positively associated with abnormal cardiac structure. PMID: 27991547
- findings reveal a novel role for miR-204/ANGPT1/TGFbetaR2 axis in tumor angiogenesis. We propose that therapeutic manipulation of miR-204 levels may represent a promising approach in breast cancer. PMID: 27703260
- VEGF plays a role in the induction of of ANGPT1 in skeletal muscle to stimulate angiogenesis. PMID: 29517203
- no significant difference in liver expression between chronic hepatitis C patients and controls PMID: 28027429
- serum Ang-2 and Ang-1 levels may help in the diagnosis of patients with lymphatic anomalies and are concordant to sirolimus response. PMID: 27990590
- Studied role of change in ratio of angiopoietin-2 (Ang-2) to angiopoietin-1 (Ang-1) levels in hantavirus ionfections. Found imbalance in ang-2:ang-1 lasted through the acute infection phase. PMID: 28734140
- Bicarbonate buffered PD fluid promotes vessel maturation via upregulation of angiopoietin-1 in vitro and in children on dialysis PMID: 29253861
- When Tie2 becomes inactivated, important molecular brakes are released in the endothelium, which in turn potentiate inflammation and vascular leakage. The ligands of Tie2, Angiopoietin-1 and Angiopoietin-2, regulate its activation status. PMID: 28582314
- These data suggest that certain DCE-MRI parameters correlate with R-ISS and adverse prognostic features of angiogenesis, such as the ratio of Angp-1/Angp-2. PMID: 28766001
- study revealed decreased levels of VEGF, ANGPT1, and MMP-9 in the early post-transplant period as compared to the baseline (BC). ANGPT2 was decreased after conditioning treatment, but tended to increase from day +7. On day +7, positive correlations between ANGPT1 level as well as MMP-9 and the time to engraftment were observed. PMID: 28956132
- These results indicate that the Angpt-Tie2 system is essential for SC integrity. The impairment of this system underlies POAG-associated pathogenesis, supporting the possibility that Tie2 agonists could be a therapeutic option for glaucoma. PMID: 28920924
- Ang-1 specifically increases circulating Gr1(+ )inflammatory monocytes and increases monocyte/macrophage retention in atherosclerotic plaques, thereby contributing to development of atherosclerosis. PMID: 28069704
- NOX2, NOX4, and mitochondrial-derived reactive oxygen species contribute to angiopoietin-1 signaling and angiogenic responses in endothelial cells. PMID: 28351775
- ANG-1, ANG-2 and TIE-2 levels were significantly increased in placenta of non-complicated ART pregnancies compared to placentas from spontaneous conception. PMID: 28238760
- study is the first one to report Ang1 capacity to induce MIP-1beta gene expression, protein synthesis and release from neutrophils, and that these effects are mediated by PI3K, p38 MAPK and MEK activation and downstream NF-kappaB activation PMID: 27632174
- In this study, we found that angiopoietins and Tie receptors were highly expressed in cervical cancer cells. Tie-2 expression in tumor cells predicted poorer prognosis.Our data support that dual inhibition of Ang-1 and Ang-2 may be an alternative target for anti-angiogenic adjuvant therapy in advanced or recurrent cervical squamous cell cancer. PMID: 28720059
- Data show that fibulin-5 strongly binds to the endothelial cell surface reducing endothelial cell viability and interfering with the signaling pathways of the Ang-1/TIE-2 receptor axis. PMID: 27304216
- Ang-1 is not a predictive and clinically relevant biomarker in pulmonary hypertension PMID: 27802345
- We could therefore conclude that angiogenesis is an important event in the development of common skin warts, and the upregulation of both Ang1 and -2 and their binding receptor Tie2 may play a role in the angiogenesis associated with the development of these lesions. PMID: 26695562
- In vitro binding assays with purified components reveal that Tie-integrin recognition is direct, and further demonstrate that the receptor binding domain of the Tie2 ligand Ang-1, but not the receptor binding domain of Ang-2, can independently associate with a5b1 or aVb3. cooperative Tie/integrin interactions selectively stimulate ERK/MAPK signaling in the presence of both Ang-1 and fibronectin PMID: 27695111
- Results uncovered ZO-1 as part of a signaling node activated by VEGF, but not Ang-1, that specifically modulates endothelial cells proliferation during angiogenesis. PMID: 26846344
- there was no immunohistochemical evidence for apoptosis or autophagy. Quantitative staining showed similar expression levels of the angiogenesis regulators VEGF-A, VEGF-receptor 2 and Angpt1 (p = 0.11), but Angpt2 was significantly lower in CKD children (p = 0.01). PMID: 27846250
- Ang-1 and -2 levels and the Ang-2/Ang-1 ratio may be promising indicators of disease activity in hemolytic uremic syndrome induced by enterohemorrhagic Escherichia coli. PMID: 26945868
- l-thyroxine increased Ang1 expression and induces bone formation, differentiation, and mineralization in U2OS and MG63 cell lines. PMID: 27569283
- Hydroxysafflor yellow A promotes angiogenesis in HUVEC cells via the angiopoietin 1/ Tie-2 signaling pathway. PMID: 27894114
- We conclude that aging shifts the balance of the Ang1/Ang2 network favouring a quiescent state. Activation of endothelial cells in aging might be necessary to enhance wound healing capacities. PMID: 27137842
- Plasma Ang-1 levels were diminished in Behcet's disease patients, especially in patients with vascular involvement. PMID: 25964071
- Ang2/Ang1 ratio might constitute a useful tool for monitoring the progression of chronic liver disease towards cirrhosis and play an important role as therapeutic target. PMID: 27956798
- Data suggest that ANGPT1 is active in tight junctions and adherens junctions in the up-regulation of pathophysiological angiogenesis in ovarian follicles in ovarian hyperstimulation syndrome. Follicular fluid from women at risk of ovarian hyperstimulation syndrome in Argentina was used in these studies. PMID: 25485810
- the results of the present study suggest that aHSCs increased the expression of Ang-1, resulting in angiogenesis in HCC tissues, thus promoting the growth and metastasis of HCC. PMID: 27358066
- Results found that MCT contributes to endothelial cell growth and tube formation via up-regulation of angiopoietin-1 expression suggesting that MCT plays an important role in pancreatic cancer angiogenesis and tumor growth via activating the angiopoietin-1 pathway. PMID: 27240355
- Angiopoietin 1 levels were significantly higher in nasopharyngeal cancer patients. PMID: 26758427
- High Ang 1 expression in hilar cholangiocarcinoma and infiltration of TIE2-expressing monocytes (TEMs) defines a subgroup of patients with beneficial tumor characteristics and prolonged survival. Low Ang 2 levels tended to inversely correlate with TEMs invasion. PMID: 27111031
- GTPCH/Ang-1 interaction in stromal fibroblasts and activation of Tie2 on breast tumor cells could play an important role in supporting breast cancer growth. PMID: 26814432
- the homeostasis of vascular endothelial function by Ang-1 and Ang-2 is disrupted in macrophage activation syndrome (MAS); the Ang-2/1 ratio was significantly elevated in the active phase of s-JIA; serum Ang-1 levels were significantly decreased in MAS, whereas the serum Ang-2 levels and the Ang-2/1 ratio were significantly elevated in MAS PMID: 26908294
- ANGPT1 may be associated with taxol resistance of nasopharyngeal carcinoma cells. PMID: 26722421
- ANGPT1, ANGPT2, and VEGF are associated with development of acute graft-versus-host disease after allogeneic hematopoietic stem cell transplantation. PMID: 26489624
- AGP1 is downregulated in non-small cell lung cancer patients compared to those with benign lung disease or no lung disease. PMID: 26908325
- In this study found that serum Ang-1 levels were significantly higher at 72 hours post-hemorrhage among aSAH patients. PMID: 26208799
- For the diagnosis of HELLP syndrome, increased levels of ET-1,M30 and Angs-1 [Angiopoietin-1] and -2 [Angiopoietin-2]appear as promising biomarkers after determination of their standardized threshold levels PMID: 26138305
- H3K9 demethylase KDM3B represses transcription of the angiogenesis regulatory gene, ANGPT1. PMID: 25413303
- Angiopoietin-1 Regulates Brain Endothelial Permeability through PTPN-2 Mediated Tyrosine Dephosphorylation of Occludin PMID: 26090670
- Genetic variations of ANGPT1 were associated with increased infarct size and disease susceptibility. PMID: 26542693
- The distribution of the other genotypes (rs2507800, rs1954727 and rs1010824 of ANGPT1 was not significantly different between patients with psoriasis vulgaris and the healthy controls. PMID: 25753570
- Malaria in pregnancy is an effect modifier of the association between Ang-1 and placental barrier thickness. PMID: 26090803
- Ang-1 disrupts TLR4 signalling, resulting in inhibition of LPS-induced inflammatory responses in endothelial cells. This inhibition occurs through selective targeting of IRAK1 and TRAF6 proteins by miR-146b-5p. PMID: 25824148
- Gingipains from the Porphyromonas gingivalis play roles in regulation of angiopoietin 1 and angiopoietin 2 in human aortic smooth muscle cells. PMID: 26283334
顯示更多
收起更多
-
亞細胞定位:Secreted.
-
數據庫鏈接:
Most popular with customers
-
YWHAB Recombinant Monoclonal Antibody
Applications: ELISA, WB, IHC, IF, FC
Species Reactivity: Human, Mouse, Rat
-
Phospho-YAP1 (S127) Recombinant Monoclonal Antibody
Applications: ELISA, WB, IHC
Species Reactivity: Human
-
-
-
-
-
-